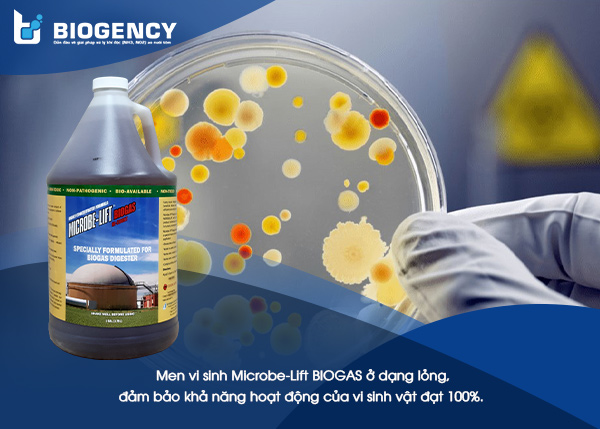
Men vi sinh Microbe-Lift BIOGAS ở dạng lỏng, đảm bảo khả năng hoạt động của vi sinh vật đạt 100%.

Men vi sinh Microbe-Lift BIOGAS có khả năng hoạt động mạnh mẽ hơn gấp 5 đến 10 lần so với vi sinh thông thường. Microbe-Lift BIOGAS giúp tăng lượng khí Biogas lên đến 50%, tăng cường hiệu suất xử lý của hệ thống xử lý nước thải. Hãy cùng Biogency tìm hiểu chi tiết hơn về sản phẩm này qua bài viết dưới đây.

Đặc điểm của vi sinh Microbe-Lift BIOGAS
Microbe-Lift BIOGAS là sản phẩm men vi sinh, ứng dụng phương pháp sinh học vào xử lý nước thải. Đây là dòng sản phẩm được nghiên cứu phát triển bởi Viện Nghiên Cứu Sinh Thái Hoa Kỳ – Ecological Laboratories, sở hữu những ưu điểm mà ít sản phẩm trên thị trường có được.

Hình 1. Men vi sinh Microbe-Lift BIOGAS được sản xuất bởi Ecological Laboratories, Mỹ.
– Chứa các chủng vi sinh kỵ khí có hoạt tính mạnh
Trong sản phẩm Microbe-Lift BIOGAS chứa nhiều loại vi sinh vật kỵ khí được chọn lọc dựa vào hoạt tính mạnh, như:
- Clostridium Butyricum
- Clostridium Satagoforme
- Desulfovibrio Vulgaris
- Desulfovibrio Aminophilus
- Geobacter Lovleyi
- Methanomethylovorans Hollandica
- Methanosarcina Barkeri
- Pseudomonas Citronellolis
Những vi sinh vật này được ứng dụng vào xử lý nước thải dựa trên phương pháp sinh học kỵ khí. Dựa vào hoạt động của chúng để ứng dụng vào phân hủy các chất hữu cơ, tăng lượng khí Biogas và giảm nồng độ H2S, giúp các công đoạn xử lý phía sau đơn giản hơn.
– Có thể hoạt động trong điều kiện độ mặn lên đến 40‰ (tương đương 4%)
Không giống với các sản phẩm vi sinh khác trên thị trường, Microbe-Lift BIOGAS chứa những chủng vi sinh vật có khả năng hoạt động trong môi trường có độ mặn cao, lên đến 40‰. Nhờ vào điều này mà vùng xử lý nước thải được mở rộng hơn, đối với những khu vực nước thải bị nhiễm mặn hoặc nguồn nước đầu vào có tính chất độ mặn cao cũng có thể được xử lý đơn giản.
– Dạng lỏng, kích hoạt nhanh, đảm bảo khả năng hoạt động 100%
Vi sinh Microbe-Lift BIOGAS được sản xuất ở dạng lỏng, nhằm đảm bảo tốc độ kích hoạt và khả năng hoạt động của các chủng vi sinh vật đạt 80% – 100%. Bên cạnh đó, quần thể vi sinh vật chứa trong sản phẩm đã được chọn lọc, có khả năng hoạt động mạnh hơn các chủng vi sinh thông thường từ 5 – 10 lần, giúp tối ưu thời gian xử lý chất ô nhiễm do đã bỏ qua giai đoạn hoạt hóa bào tử thành vi sinh.
Hình 2. Men vi sinh Microbe-Lift BIOGAS ở dạng lỏng, đảm bảo khả năng hoạt động của vi sinh vật đạt 100%.
Sản phẩm ở dạng lỏng, được đóng gói và bảo quản trong chai nhựa (với chai 1 gallon = 3.785 lít).
Khả năng tăng khí Biogas của Men vi sinh Microbe-Lift BIOGAS
Microbe-Lift BIOGAS là dòng men vi sinh được nghiên cứu và phát triển chuyên dùng cho quá trình xử lý sinh học kỵ khí. Ngoài ra, sản phẩm cũng sở hữu nhiều ưu điểm vượt trội, mang tính ứng dụng cao trong quá trình xử lý nước thải.
– Tăng lượng khí Biogas lên đến 50% và giảm nồng độ H2S sinh ra
Microbe-Lift BIOGAS là sản phẩm chuyên biệt có khả năng làm tăng lượng khí Biogas từ 30 – 50%. Lượng khí Biogas sinh ra càng nhiều thì những công việc sau trong quá trình xử lý nước thải sẽ đỡ vất vả hơn. Ngoài ra, sản phẩm vi sinh này cũng có khả năng giảm thiểu đi những khí độc, cụ thể là khí H2S. Việc xử lý khí H2S là vô cùng cần thiết, bởi nó vô cùng độc hại đối với môi trường và ảnh hưởng trực tiếp đến sức khỏe con người.

Hình 3. Microbe-Lift BIOGAS có khả năng hoạt động mạnh mẽ nhờ vào những ưu điểm nổi bật.
– Sử dụng được cho tất cả các loại nước thải chứa hàm lượng chất hữu cơ cao
Sản phẩm Microbe-Lift BIOGAS phù hợp với tất cả các loại nước thải khác nhau như:
- Nước thải công nghiệp, từ các ngành như: Cao su, chế biến thực phẩm, chăn nuôi, dệt nhuộm, dầu ăn, sản xuất bia,…
- Nước thải trong ngành chế biến thủy sản.
- .v.v…
– Thúc đẩy quá trình phân hủy sinh học trong toàn hệ thống
Trong nước thải luôn tồn tại những hợp chất hữu cơ khó xử lý, gây ảnh hưởng đến chất lượng của nước thải đầu ra. Microbe-Lift BIOGAS giúp thúc đẩy quá trình phân hủy những chất hữu cơ phức tạp như Benzene-, Toluene- hay Xylene- (BTX). Từ đó, tăng hiệu suất xử lý của hệ thống xử lý nước thải, giúp nước thải đạt tiêu chuẩn đầu ra.
– Phục hồi nhanh hệ thống xử lý nước thải sau sự cố
Trong quá trình xử lý nước thải, việc vận hành hệ thống xử lý đôi khi sẽ gặp phải những trường hợp bất khả kháng như dịch bệnh, bão lũ, tải lượng đầu vào thay đổi đột ngột,… Đó là những lý do làm cho hệ thống gặp sự cố, các chủng vi sinh thông thường sẽ không còn khả năng hoạt động để xử lý các chất ô nhiễm. Đặc biệt, Microbe-Lift BIOGAS có thể tăng khí Biogas, giúp hệ thống xử lý nước thải được phục hồi nhanh hơn.
Khi gặp phải những trường hợp như vậy, điều cấp thiết nhất là cần phải nuôi cấy lại hệ vi sinh trong thời gian ngắn. Microbe-Lift BIOGAS có nhiều ưu điểm từ các chủng vi sinh: Không cần ngâm ủ, nhân đôi chỉ sau 30 phút, hoạt tính mạnh và khả năng thích nghi cao… Do đó, Microbe-Lift BIOGAS là sản phẩm men vi sinh được ưa chuộng để nuôi cấy và nhanh chóng phục hồi hệ vi sinh kỵ khí cho hệ thống nước thải sau sự cố.

Hình 4. Men vi sinh Microbe-Lift BIOGAS giúp tăng khí Biogas hiệu quả và nâng cao hiệu suất xử lý sinh học của toàn hệ thống xử lý nước thải.
Cách sử dụng sản phẩm vi sinh Microbe-Lift BIOGAS
– Hướng dẫn sử dụng Microbe-Lift BIOGAS
Trong tháng đầu tiên nuôi cấy vi sinh:
- Ngày 1 và 2: sử dụng từ 6 – 60 ml/m3.
- Ngày 3 đến 7: sử dụng từ 3 – 30 ml/m3.
- Ngày 8 đến 30: sử dụng từ 0,3 – 3,4 ml/m3.
Duy trì ổn định và hiệu suất cho hệ thống:
- Liều lượng từ 0.15 – 2 ml/m3.
- Bổ sung 1 tuần/lần.
Tuy nhiên, tùy thuộc vào tính chất nước thải và đặc điểm của hệ thống mà liều lượng sẽ thay đổi cho phù hợp.
Ngoài ra, có thể kết hợp Microbe-Lift BIOGAS và Microbe-Lift SA để tăng thêm hiệu suất xử lý.
– Điều kiện hoạt động của vi sinh
Để sản phẩm mang lại hiệu quả tối đa, tiết kiệm được thời gian, chi phí và công sức cho các giai đoạn xử lý sau, cần đảm bảo được các điều kiện hoạt động của vi sinh:
- Độ pH: 4 – 9.
- Nhiệt độ: 4 độ C đến 40 độ C.
- Tỷ lệ BOD/COD > 60%.
- Độ mặn dưới 40 ‰ (khoảng 4%).
- Bảo quản nhiệt độ từ 10 độ C đến 40 độ C.
—
Microbe-Lift BIOGAS là sản phẩm men vi sinh giúp tăng khí Biogas hiệu quả nhất trên thị trường. Sản phẩm đang được phân phối độc quyền bởi BIOGENCY – chuyên cung cấp giải pháp và sản phẩm sinh học xử lý môi trường. Liên hệ ngay đến HOTLINE 0909 538 514 để được tư vấn chi tiết hơn về sản phẩm và giải pháp xử lý nước thải hiệu quả nhất!
>>> Xem thêm: Đo lường hiệu suất xử lý hầm Biogas bằng 6 chỉ tiêu
